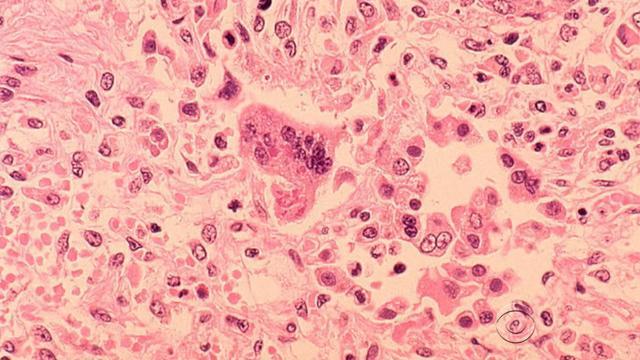
en-0130-measles-338750-640x360.jpg

Fill That Truck Food Drive
This March, WCCO-TV is honored to partner with Merrick Community Services for the Fill That Truck Food Drive.
Watch CBS News

This March, WCCO-TV is honored to partner with Merrick Community Services for the Fill That Truck Food Drive.

Before severe weather hits, it's important for your family to have an emergency plan and to practice it annually. Check out our Tornado Preparedness Kit.

In the basement of the Minnesota History Center, you'll find corridors of giant blue cabinets that are guarded by lock and key.

Duluth is known for its scenic views across the city, but one location stands out from the rest.

From the Twin Cities to the North Shore, here are the holiday tree lightings and parades in 2024 in the Twin Cities and in Greater Minnesota.

At Wonderland Mushroom Dispensary on Grand Avenue, several types of fungi fill the store.
Three children in the Twin Cities were confirmed to have measles this week, and two of them required hospitalization, health officials said.

The Aquatennial is the civic celebration of the City of Minneapolis. The annual event, which this year will take place from July 24 to July 27, features multiple events, including the Torchlight Parade, and culminates in a fireworks show.

The hot weather means a lot of Minnesotans are trying to find ways to beat the heat without breaking the bank.

The Minnesota Department of Transportation says the next few days' worth of hot weather in Minnesota and the Twin Cities could result in pavement buckling along certain stretches.

Stormwater drags nutrients like phosphorus into drains, which lead to lakes and streams hurting water quality. They can also create algae blooms. So how can you reduce runoff at home? There's a handful of options, some of which can be cost-free.

Gov. Tim Walz and U.S. Sen. Amy Klobuchar took an aerial tour of the region earlier in the day to survey flood damage. Thereafter, Walz said he would potentially call a special session if the damage costs end up higher than the relief money currently available.

The rain is slowing down but the rivers are still rising. Just south of Carver, in Jordan, the Minnesota River is taking over the road.

Here's your 2024 guide to Pride Month events in the Twin Cities and greater Minnesota.

When you start a debt management plan, your credit cards are closed. In the short term, that does negatively impact your credit score, but once consumers finish paying down all the debt, they typically see a score increase of about 84 points.

The sea lions are part of a new exhibit and show at the zoo, which spent months coordinating the transfer of the pinnipeds from other zoos and aquariums in Texas and New York.

Johnny Le, 32, was charged with one count of third-degree criminal sexual conduct, according to a complaint filed in Dakota County on Monday.

Police in Eagan, Minnesota say a teen girl who went missing overnight has been found safe.

Minnesota is joining a lawsuit filed against a Twin Cities construction company after its management allegedly fired a woman who reported being sexually harassed and raped on the job by a co-worker.

A spring snowstorm that's expected to bring plowable snow to Minnesota and western Wisconsin by Wednesday morning is prompting multiple schools to close.

In 2023, the US exported nearly $90 billion dollars in agricultural products to Canada, Mexico and China.

The Oscar-winning film "The Brutalist" was inspired in part by St. John's Abbey Church, thanks to a book written by a monk who worked with architect Marcel Breuer.

A sign overlooking the scenic bluffs of the Root Valley in southeastern Minnesota identifies Houston, a small town that goes big when it comes to owls.

A spring snowstorm that's expected to bring plowable snow to Minnesota and western Wisconsin by Wednesday morning is prompting multiple schools to close.

Trump's cutbacks of federal funding have led to uncertainty for nonprofits that help thousands of women, children.

More girls and women will soon be able to show their skills on the football field.

A new audit of the November election won by President Donald Trump in swing-state Wisconsin has found that not a single vote was counted incorrectly, altered or missed by tabulating machines.

An hour east of the Twin Cities, Amery's mayor is crediting the town's growth in part to the bridge in Stillwater and Highway 64, which cut the route to St. Paul down by 20 minutes.

The college, which was founded in 1892 in Ashland, was struggling financially amidst declining enrollment and soaring costs.

Wisconsin's second-oldest prison that was built in the 1800s would finally be shuttered under a new plan from Gov. Tony Evers.

Two men accused of sexually assaulting a central Minnesota college student have been arrested.

A decades-long Minneapolis firefighter is now fighting another battle of his own. Six months ago, Mark Lakosky was diagnosed with multiple myeloma.

A central Minnesota deputy was unhurt when a man fired a shotgun at him during a standoff on Saturday, authorities said.

It's not harvest season in Minnesota, but a local organization is working to support and build up Black and Brown farmers across the state year-round.

There can be reasons to put off going to treatment, but two friends are removing one big barrier.

In 2023, the US exported nearly $90 billion dollars in agricultural products to Canada, Mexico and China.

As Canada and Mexico make plans for reciprocal tariffs on U.S. goods, Canadian Prime Minister Justin Trudeau calls President Trump's move "a very dumb thing to do."

Weeks into a whirlwind second term in office, President Trump will address Congress and the country with the economy in focus.

President Trump will address a joint session of Congress tonight, marking his first speech to both chambers since he returned to office. Here's how to watch his 2025 address.

Starting Tuesday, Trump said most goods coming from Mexico and Canada will get hit with a 25% tariff.

Sales and profits slipped for Minneapolis-based Target during the crucial holiday quarter as customers held back on spending and the company said there will be "meaningful pressure" on its profits to start the year because of tariffs and other costs.

Rideshare drivers in the Twin Cities joined lawmakers and labor leaders at the Minnesota State Capitol on Tuesday to announce a push for unionization rights.

Tax season is underway, and Minnesotans who have filed may be eager to know the status of their refund.

From a deep freeze, all the way to the 50s, the drastic change in temperatures in the Twin Cities is the perfect recipe for potholes.

An hour east of the Twin Cities, Amery's mayor is crediting the town's growth in part to the bridge in Stillwater and Highway 64, which cut the route to St. Paul down by 20 minutes.

Johnny Le, 32, was charged with one count of third-degree criminal sexual conduct, according to a complaint filed in Dakota County on Monday.

Minnesota is joining a lawsuit filed against a Twin Cities construction company after its management allegedly fired a woman who reported being sexually harassed and raped on the job by a co-worker.

Minneapolis Park Police are investigating after five trees were illegally cut down and others were damaged by chainsaw near Cedar Lake last month.

A man is hospitalized with a potentially life-threatening injury after a shooting in Minneapolis, police say.

The man allegedly connected to a fatal crash in the Twin Cities that killed an 11-year-old girl has been charged with third-degree assault in a separate incident.

Why do we get bored? How should we overcome it? Good Question.

Minnesota's Mayo Clinic has earned another accolade, with Newsweek naming the Rochester health system the world's best hospital in its 2025 rankings.

The drinks are often low in calories and sugar and high in fiber, claiming to support digestive health.

Democratic Minnesota U.S. Sen. Tina Smith says she some major concerns about the Republican-backed plan that could cut $1.5 trillion in federal spending over the next decade, possibly impacting Medicaid.

Some Republicans in the Minnesota Legislature sounded the alarm about potential federal cuts to Medicaid, which could be at risk after the U.S. House passed a budget framework that includes slashing federal spending.

The Oscar-winning film "The Brutalist" was inspired in part by St. John's Abbey Church, thanks to a book written by a monk who worked with architect Marcel Breuer.

Hip hop star Nelly is planning on bringing the heat to Target Field in Minneapolis this summer.

Carl Dean, the husband of Dolly Parton, died Monday in Nashville, the singer said in a statement.

"Anora" won big at the 2025 Oscars. Here's the full list of who won and was nominated for this year's Academy Awards.

Hollywood's biggest stars turned out for the 97th annual Academy Awards. Here is what to know and how to watch the 2025 Oscars.

The last quarterfinal of the boys' state hockey tournament on Thursday will be powerhouse defending champion Edina versus newcomer Rogers, making their state debut.

The Minnesota Vikings declined to apply the franchise tag to Sam Darnold before Tuesday's deadline, meaning the quarterback is likely to hit free agency next week.

Hear from Tartan men's basketball coach Mark Klingsporn, who just won his 700th career game. Plus, see which boys hockey teams from Class AA have stamped their ticket to the state tournament.

The injury-thinned Minnesota Wild could use a boost in their push to return to the playoffs.

Minnesota guard Mara Braun won't return to play this season in preservation of a year of eligibility after breaking her right foot for the second straight season.

Minnesota Attorney General Keith Ellison is joining other states in suing the Trump administration over a number of his executive orders.

The Minnesota Attorney General is joining other states in suing the Trump administration over a number of his executive orders.

With social media proving dangerous in multiple ways for children, an expert breaks down what warning signs parents should look for.

Many public health officials have called for warning labels on social media. The risk includes anxiety, depression, as well as violent outcomes, including kidnappings. In Talking Points, Esme Murphy spoke with Dr. Steve Webb, @dr.stevewebb2542 , whose book draws on his experience as a police officer and Superintendent of an Illinois School District about online safety tips for parents.

The Minnesota Department of Agriculture says it's trying to get clarity on the cuts.

If you've been to the University of Minnesota, you can't miss the Weisman Art Museum. It stands out in more ways than one.

How about spending Valentine's Day, in a dome? You can do it in Pine City. The Sweetbriar Ridge offers couples a unique glamping getaway.

If you've been to southeastern Minnesota, you've likely come across Sugar Loaf Bluff.

In the basement of the Minnesota History Center, you'll find corridors of giant blue cabinets that are guarded by lock and key.

The story behind the St. James Hotel is simple: 11 business owners needed a place for people to stay when they came to town. Likely none of them envisioned their establishment would one day end up on the National Register of Historic Places.

Why do we get bored? How should we overcome it? Good Question.

The drinks are often low in calories and sugar and high in fiber, claiming to support digestive health.

A survey found 40% percent of people don't always put their phones on airplane mode while on a flight, while 17% percent say they never do it.

No matter the age, there's one school subject that just doesn't add up for many people, and trying to solve it can bring nerves and even fear.

There's a chance you've caught some sort of bug this season. So why do we sleep so much when we get sick? There's a possible link between rest and recovery.

Six Minnesota Vikings made the initial roster for the 2025 Pro Bowl Games, the most in 15 years.

Regions Hospital and Children's Minnesota share photos of their tiniest patients dressed to the nines for Halloween.

Minnesotans got a great view of the northern lights Thursday night due to the arrival of a severe geomagnetic storm.

Minnesotans got a great view of the northern lights Monday night.

Storms ripped through parts of Minnesota and western Wisconsin on Thursday evening. There were several reports of tornadoes and trees were downed in the metro and beyond, including in Cottage Grove, Anoka, Champlin and Fridley.

WCCO meteorologist Chris Shaffer says rain will start transitioning to snow soon and will cause dangerous conditions on Minnesota roads.

In Minnesota, weather can be all over the place. Here at WCCO, we want to give you what you need to prepare for what's happening next.

Rainfall in the Twin Cities late Tuesday will turn to plowable snow overnight, says meteorologist Chris Shaffer.

A spring storm is set to bring multiple inches of snow to the metro on Wednesday.

WCCO meteorologist Lisa Meadows says parts of Minnesota, including the Twin Cities, should gear up for a spring storm that could drop several inches of snow by midday Wednesday.

The last quarterfinal of the boys hockey state tournament on Thursday will be powerhouse defending champion Edina versus newcomer Rogers. Ren Clayton met the team making their state debut.

WCCO meteorologist Chris Shaffer says rain will start transitioning to snow soon and will cause dangerous conditions on Minnesota roads.

"The Brutalist" is based on a world-renowned architect who captured the attention of Hollywood and designed the Abbey Church at St. John's University. Jeff Wagner and Photojournalist Nick Lunemann take us to Collegeville.

Someone shot and killed a Champlin Park High School student this weekend. Now, his parents are demanding justice. David Schuman sat down with them in what was an emotional interview.

President Trump will be making his speech to a joint session of Congress Tuesday night. Two of Minnesota's congressional delegation are bringing fired federal workers as their guests. Esme Murphy has the details.